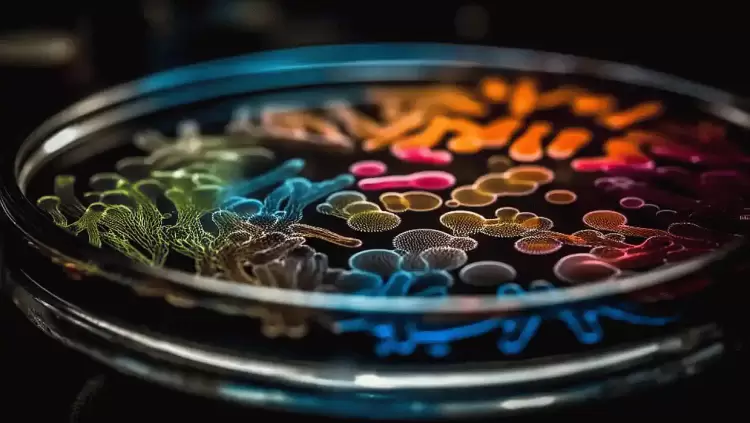
Μια νέα πιθανή κατηγορία αντιβιοτικών ανακάλυψαν ερευνητές Μια νέα πιθανή κατηγορία αντιβιοτικών ανακάλυψαν ερευνητές

Οι ερευνητές εντόπισαν το μόριο lariocidin, που εντάσσεται σε μια νέα κατηγορία αντιβιοτικών. Η ανακάλυψη ανταποκρίνεται στην κρίσιμη ανάγκη για νέα φάρμακα που θα καταπολεμήσουν τη μικροβιακή αντοχή, μια από τις σημαντικότερες απειλές για τη δημόσια υγεία. Όπως επισημαίνουν, το νέο μόριο είναι ελπιδοφόρο ως ένα πρώιμο φαρμακευτικό μόριο, επειδή επιτίθεται στα βακτήρια με τρόπο διαφορετικό από τα άλλα αντιβιοτικά.
Το μόριο παράγεται από έναν τύπο βακτηρίων που ονομάζεται Paenibacillus, τον οποίο οι ερευνητές ανέκτησαν από δείγμα εδάφους που συλλέχθηκε από μια αυλή. Εκτός από τον μοναδικό τρόπο δράσης του και τη δραστηριότητά του εναντίον βακτηρίων ανθεκτικών στα φάρμακα, οι ερευνητές είναι αισιόδοξοι για το μόριο αυτό επειδή πληροί πολλά από τα σωστά κριτήρια: δεν είναι τοξικό για τα ανθρώπινα κύτταρα, δεν είναι ευαίσθητο στους υπάρχοντες μηχανισμούς αντοχής στα αντιβιοτικά και λειτουργεί επίσης καλά σε ένα ζωικό μοντέλο λοίμωξης.
«Πρόκειται για ένα νέο μόριο με νέο τρόπο δράσης», επισημαίνει ο Τζέρι Ράιτ, επικεφαλής της έρευνας και καθηγητής στο Πανεπιστήμιο McMaster. «Είναι ένα μεγάλο βήμα προς τα εμπρός για εμάς», προσθέτει.
Οι ερευνητές επικεντρώνονται τώρα στην εξεύρεση τρόπων τροποποίησης του μορίου και παραγωγής του σε ποσότητες αρκετά μεγάλες, ώστε να καταστεί δυνατή η κλινική ανάπτυξη.
Σημειώνεται ότι έχουν περάσει σχεδόν τρεις δεκαετίες από τότε που μια νέα κατηγορία αντιβιοτικών κυκλοφόρησε στην αγορά.
Πηγή: ΑΠΕ-ΜΠΕ